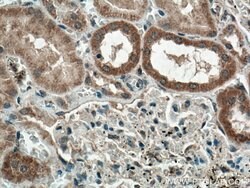
Sclerostin Rabbit anti-Human, Polyclonal, Proteintech:Antibodies:Primary

missing translation for 'onlineSavingsMsg'
Learn More
Learn More
Sclerostin Rabbit anti-Human, Polyclonal, Proteintech
Rabbit Polyclonal Antibody
€ 145.00 - € 410.00
Specifications
| Antigen | Sclerostin |
|---|---|
| Concentration | 0.38 mg/mL |
| Applications | Immunohistochemistry (Paraffin), Western Blot |
| Classification | Polyclonal |
| Conjugate | Unconjugated |
| Product Code | Brand | Quantity | Price | Quantity & Availability | |||||
|---|---|---|---|---|---|---|---|---|---|
| Product Code | Brand | Quantity | Price | Quantity & Availability | |||||
|
16831485
|
Proteintech
21933-1-AP-20UL |
20 μL |
€ 145.00
20µL |
Please sign in to purchase this item. Need a web account? Register with us today! | |||||
|
16821485
|
Proteintech
21933-1-AP-150UL |
150 μL |
€ 410.00
150µL |
Please sign in to purchase this item. Need a web account? Register with us today! | |||||
Description
Negative regulator of bone growth that acts through inhibition of Wnt signaling and bone formation.Specifications
| Sclerostin | |
| Immunohistochemistry (Paraffin), Western Blot | |
| Unconjugated | |
| Rabbit | |
| Human | |
| Q9BQB4 | |
| 50964 | |
| Sclerostin Fusion Protein Ag16567 | |
| Primary | |
| -20°C | |
| SOST |
| 0.38 mg/mL | |
| Polyclonal | |
| Liquid | |
| RUO | |
| PBS with 50% glycerol and 0.02% sodium azide; pH 7.3 | |
| sclerosteosis, Sclerostin, SOST, VBCH | |
| SOST | |
| IgG | |
| Antigen Affinity Chromatography | |
| Antibody |
Spot an opportunity for improvement?Share a Content Correction
Product Content Correction
Your input is important to us. Please complete this form to provide feedback related to the content on this product.
Product Title